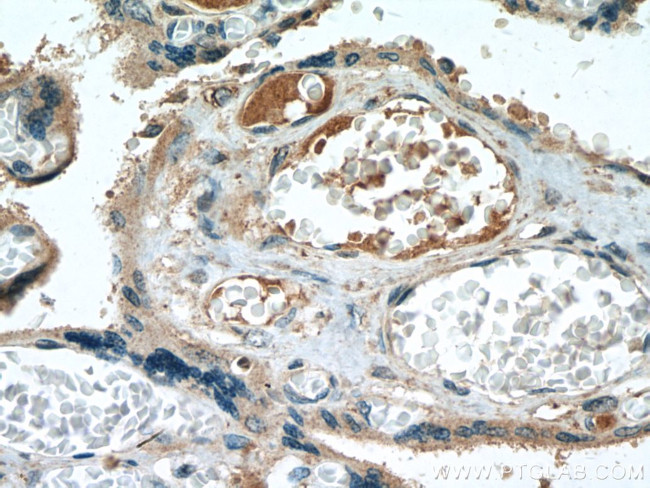
CALHM2 Antibody in Immunohistochemistry (Paraffin) (IHC (P))

Search
Proteintech
CALHM2 Polyclonal Antibody
{{$productOrderCtrl.translations['antibody.pdp.commerceCard.promotion.promotions']}}
{{$productOrderCtrl.translations['antibody.pdp.commerceCard.promotion.viewpromo']}}
{{$productOrderCtrl.translations['antibody.pdp.commerceCard.promotion.promocode']}}: {{promo.promoCode}} {{promo.promoTitle}} {{promo.promoDescription}}. {{$productOrderCtrl.translations['antibody.pdp.commerceCard.promotion.learnmore']}}
产品信息
19931-1-AP
种属反应
宿主/亚型
分类
类型
抗原
偶联物
形式
浓度
规格
纯化类型
保存液
内含物
保存条件
运输条件
产品详细信息
Immunogen sequence: KHYCSPLSY RQEAYWAQYR ANEDQLFQRT AEVHSRVLAA NNVRRFFGFV ALNKDDEELI ANFPVEGTQP RPQWNAITGV YLYRENQGLP LYSRLHKWAQ GLAGNGAAPD NVEMALLPS (206-323 aa encoded by BC000039)
靶标信息
CALHM2, also named as FAM26B, is a pore-forming subunit of a voltage-gated ion channel. It is a critical ATP-releasing channel that modulates neural activity and as a potential risk factor of depression. There are three isoforms of CALHM2 with calculated MW 36 kDa, 24 kDa and 22 kDa. It is about 32-36 kDa in western blot with membrane protein extracted lysate.
仅用于科研。不用于诊断过程。未经明确授权不得转售。
生物信息学
蛋白别名: calcium homeostasis modulator 2; Calcium homeostasis modulator protein 2; family with sequence similarity 26, member B; Protein FAM26B; unnamed protein product
基因别名: 2810048G17Rik; CALHM2; FAM26B; RGD1308276
UniProt ID: (Human) Q9HA72, (Rat) Q5RJQ8, (Mouse) Q8VEC4
Entrez Gene ID: (Human) 51063, (Rat) 294019, (Mouse) 72691